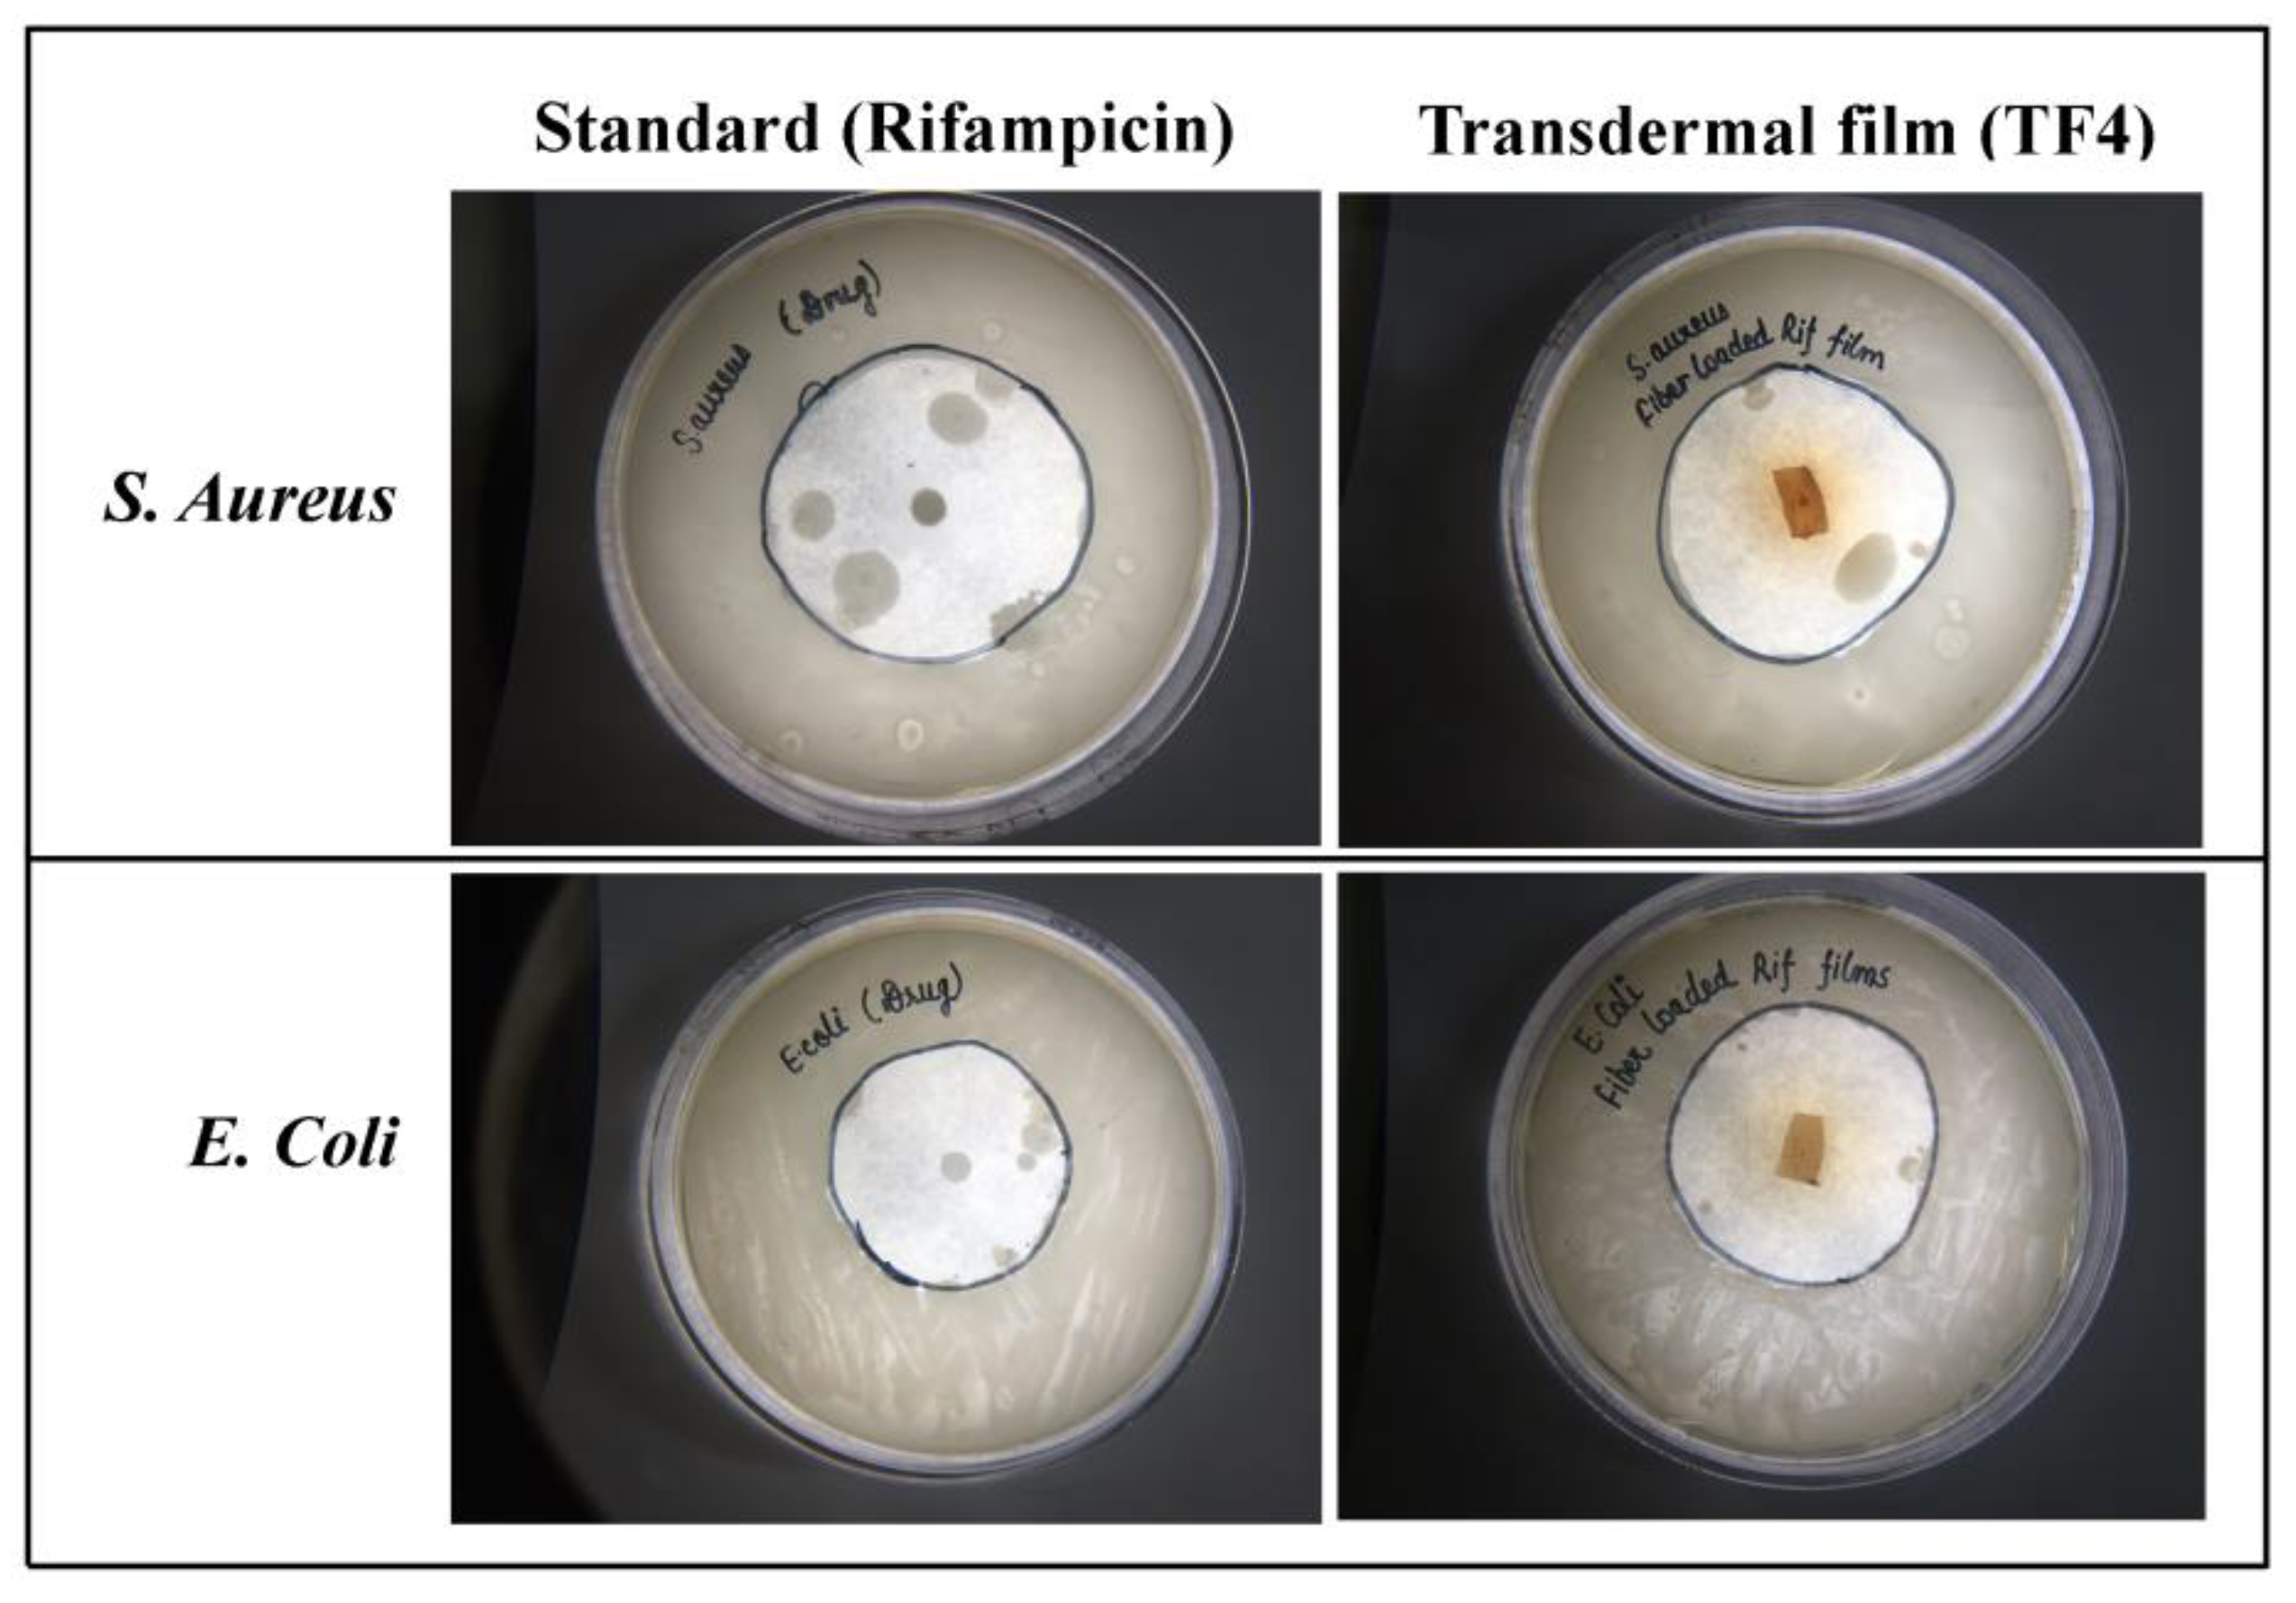
Membranes 11 00007 g007 Membranes 11 00007 g007

Rifampicin-Loaded Alginate-Gelatin Fibers Incorporated within Transdermal Films as a Fiber-in-Film System for Wound Healing Applications
Abstract
1. Introduction
2. Materials and Methods
2.1. Solvents and Reagents
2.2. Experimental
Preparation of Rifampicin Fiber-Loaded Transdermal Films
3. Physicochemical Evaluation of Fiber-Loaded Transdermal Films
3.1. Film Thickness and Weight Variation
3.2. pH Measurement
3.3. Determination of Drug Content
3.4. Moisture Content
3.5. Moisture Uptake Study
3.6. Folding Endurance
3.7. Mechanical Properties
3.8. Swelling Index
3.9. Water Vapour Transmission Rate (WVTR)
4. Characterization of Fiber Loaded Transdermal Films
4.1. Morphological Analysis
4.2. XRD
4.3. FTIR
4.4. In Vitro Release Studies
4.5. In Vitro Skin Permeation
4.6. Antimicrobial Studies
4.7. In Vivo Animal Studies
5. Results and Discussion
5.1. Physicochemical Evaluation of Transdermal Films
5.1.1. Mechanical Properties
5.1.2. Swelling Ratio
5.1.3. Water Vapor Transmission Rate (WVTR)
5.2. Characterization of Transdermal Films
5.2.1. Morphological Analysis
5.2.2. XRD
5.2.3. FTIR
5.2.4. In Vitro Drug Release
5.2.5. In Vitro Permeation
5.2.6. Antimicrobial studies
5.2.7. In Vivo Studies
6. Remarks and Conclusions
Author Contributions
Funding
Institutional Review Board Statement
Informed Consent Statement
Acknowledgments
Conflicts of Interest
Abbreviations
| nm | Nano meter |
| N/mm2 | Newton per square millimeter |
| Wi | Initial weight |
| Wd | Constant weight |
| TF | Transdermal films |
| PVA | Poly-vinyl alcohol |
| SD | Standard deviation |
| UV | Ultra violet |
| WVTR | Water vapor transmission rate |
| kV | Kilo volt |
| % | Percent |
| Ɵ | Theta |
References
- Sorg, H.; Tilkorn, D.J.; Hager, S.; Hauser, J.; Mirastschijski, U. Skin wound healing: An update on the current knowledge and concepts. Eur. Surg. Res. 2017, 58, 81–94. [Google Scholar] [CrossRef] [PubMed]
- Notodihardjo, S.C.; Morimoto, N.; Munisso, M.C.; Le, T.M.; Mitsui, T.; Kakudo, N.; Kusumoto, K. A comparison of the wound healing process after application of three dermal substitutes with or without basic fibroblast growth factor impregnation in diabetic mice. J. Plast. Reconstr. Aesthet. Surg. 2020, 73, 1547–1555. [Google Scholar] [CrossRef] [PubMed]
- Alven, S.; Nqoro, X.; Aderibigbe, B.A. Polymer-Based Materials Loaded with Curcumin for wound healing applications. Polymers 2020, 12, 2286. [Google Scholar] [CrossRef] [PubMed]
- Shi, J.; Barakat, M.; Chen, D.; Chen, L. Bicellular tight junctions and wound healing. Int. J. Mol. 2018, 19, 3862. [Google Scholar] [CrossRef]
- Bao, P.; Kodra, A.; Tomic-Canic, M.; Golinko, M.S.; Ehrlich, H.P.; Brem, H. The role of vascular endothelial growth factor in wound healing. J. Surg. Res. 2009, 153, 347–358. [Google Scholar] [CrossRef]
- Spampinato, S.F.; Caruso, G.I.; De Pasquale, R.; Sortino, M.A.; Merlo, S. The treatment of impaired wound healing in diabetes: Looking among old drugs. Pharmaceuticals 2020, 13, 60. [Google Scholar] [CrossRef]
- Negut, I.; Grumezescu, V.; Grumezescu, A.M. Treatment strategies for infected wounds. Molecules 2018, 23, 1–23. [Google Scholar] [CrossRef]
- Sen, C.K.; Gordillo, G.M.; Roy, S.; Kirsner, R.; Lambert, L.; Hunt, T.K.; Longaker, M.T. Human skin wounds: A major and snowballing threat to public health and the economy. Wound Repair Regen 2009, 17, 763–771. [Google Scholar] [CrossRef]
- Zhong, Y.; Xiao, H.; Seidi, F.; Jin, Y. Natural polymer-based antimicrobial hydrogels without synthetic antibiotics as wound dressings. Biomacromolecules 2020, 21, 2983–3006. [Google Scholar] [CrossRef]
- Tottoli, E.M.; Dorati, R.; Genta, I.; Chiesa, E.; Pisani, S.; Conti, B. Skin wound healing process and new emerging technologies for skin wound care and regeneration. Pharmaceutics 2020, 12, 735. [Google Scholar] [CrossRef]
- Rafati, Z.; Sirousazar, M.; Hassan, Z.M.; Kheiri, F. Honey-loaded egg white/poly (vinyl alcohol)/clay bionanocomposite hydrogel wound dressings: In vitro and in vivo evaluations. J. Polym. Environ. 2020, 28, 32–46. [Google Scholar] [CrossRef]
- Wang, Y.; Armato, U.; Wu, J. Targeting tunable physical properties of materials for chronic wound care. Front. Bioeng. Biotechnol. 2020, 8, 584. [Google Scholar] [CrossRef] [PubMed]
- Briquez, P.S.; Hubbell, J.A.; Martino, M.M. Extracellular matrix-inspired growth factor delivery systems for skin wound healing. Adv. Wound Care 2015, 4, 479–489. [Google Scholar] [CrossRef] [PubMed]
- Sharma, A.; Puri, V.; Kumar, P.; Singh, I. Biopolymeric, nanopatterned, fibrous carriers for wound healing applications. Curr. Pharm. Des. 2020, 26, 4894–4908. [Google Scholar] [CrossRef] [PubMed]
- Sharma, A.; Mittal, A.; Puri, V.; Kumar, P.; Singh, I. Curcumin-loaded, alginate–gelatin composite fibers for wound healing applications. 3 Biotech 2020, 10, 1–13. [Google Scholar] [CrossRef]
- Jacob, J.; Haponiuk, J.T.; Thomas, S.; Gopi, S. Biopolymer based nanomaterials in drug delivery systems: A review. Mater. Today Chem. 2018, 9, 43–55. [Google Scholar] [CrossRef]
- Kumar, S.S.D.; Rajendran, N.K.; Houreld, N.N.; Abrahamse, H. Recent advances on silver nanoparticle and biopolymer-based biomaterials for wound healing applications. Int. J. Biol. Macromol. 2018, 115, 165–175. [Google Scholar] [CrossRef]
- Ulery, B.D.; Nair, L.S.; Laurencin, C.T. Biomedical applications of biodegradable polymers. J. Polym. Sci. B Polym. Phys. 2011, 49, 832–864. [Google Scholar] [CrossRef]
- Islam, S.; Bhuiyan, M.R.; Islam, M.N. Chitin and chitosan: Structure, properties and applications in biomedical engineering. J. Polym. Environ. 2017, 25, 854–866. [Google Scholar] [CrossRef]
- Bakhsheshi-Rad, H.R.; Hadisi, Z.; Ismail, A.F.; Aziz, M.; Akbari, M.; Berto, F.; Chen, X.B. In Vitro and in vivo evaluation of chitosan-alginate/gentamicin wound dressing nanofibrous with high antibacterial performance. Polym. Test. 2020, 82, 106298. [Google Scholar] [CrossRef]
- Zahiri, M.; Khanmohammadi, M.; Goodarzi, A.; Ababzadeh, S.; Farahani, M.S.; Mohandesnezhad, S.; Ai, J. Encapsulation of curcumin loaded chitosan nanoparticle within poly (ε-caprolactone) and gelatin fiber mat for wound healing and layered dermal reconstitution. Int. J. Biol. Macromol. 2020, 153, 1241–1250. [Google Scholar] [CrossRef] [PubMed]
- Amanzadi, B.; Mirzaei, E.; Hassanzadeh, G.; Mahdaviani, P.; Boroumand, S.; Abdollahi, M.; Abdolghaffari, A.H.; Majidi, R.F. Chitosan-based layered nanofibers loaded with herbal extract as wound-dressing materials on wound model studies. Biointerface Res. Appl. Chem. 2019, 9, 3979–3986. [Google Scholar]
- Kathe, K.; Kathpalia, H. Film forming systems for topical and transdermal drug delivery. Asian J. Pharm. Sci. 2017, 12, 487–497. [Google Scholar] [CrossRef] [PubMed]
- de Barros, N.R.; Ahadian, S.; Tebon, P.; Rudge, M.V.C.; Barbosa, A.M.P.; Herculano, R.D. High absorption dressing composed of natural latex loaded with alginate for exudate control and healing of diabetic wounds. Mater. Sci. Eng. C 2020, 119, 111589. [Google Scholar] [CrossRef]
- Goller, S.; Turner, N.J. The antimicrobial effectiveness and cytotoxicity of the antibiotic-loaded chitosan: Ecm scaffolds. Appl. Sci. 2020, 10, 3446. [Google Scholar] [CrossRef]
- Rohner, N.A.; Nguyen, D.; von Recum, H.A. Affinity effects on the release of non-conventional antifibrotics from polymer depots. Pharmaceutics 2020, 12, 275. [Google Scholar] [CrossRef]
- Bediako, J.K.; Lin, S.; Sarkar, A.K.; Zhao, Y.; Choi, J.W.; Song, M.H.; Yun, Y.S. Benignly-fabricated crosslinked polyethylenimine/calcium-alginate fibers as high-performance adsorbents for effective recovery of gold. J. Clean Prod. 2020, 252, 119389. [Google Scholar] [CrossRef]
- Dong, Z.; Wang, Q.; Du, Y. Alginate/gelatin blend films and their properties for drug controlled release. J. Membr. Sci. 2006, 280, 37–44. [Google Scholar] [CrossRef]
- Chiaoprakobkij, N.; Seetabhawang, S.; Sanchavanakit, N.; Phisalaphong, M. Fabrication and characterization of novel bacterial cellulose/alginate/gelatin biocomposite film. J. Biomater Sci. Polym. Ed. 2019, 30, 961–982. [Google Scholar] [CrossRef]
- Shi, Y.; Wei, Z.; Zhao, H.; Liu, T.; Dong, A.; Zhang, J. Electrospinning of ibuprofen-loaded composite nanofibers for improving the performances of transdermal patches. J. Nanosci. Nanotechnol. 2013, 13, 3855–3863. [Google Scholar] [CrossRef]
- Gajendiran, M.; Divakar, S.; Raaman, N.; Balasubramanian, S. In vitro drug release behavior, mechanism and antimicrobial activity of rifampicin loaded low molecular weight PLGA-PEG-PLGA triblock copolymeric nanospheres. Curr. Drug Deliv. 2013, 10, 722–731. [Google Scholar] [CrossRef] [PubMed]
- Sakugawa, K.; Ikeda, A.; Takemura, A.; Hirokuni, O. Simplified method for estimation of composition of alginates by FTIR. Appl. Polym. Sci. 2004, 93, 1372–1377. [Google Scholar] [CrossRef]
- Agrawal, S.; Ashokraj, Y.; Bharatam, P.V.; Pillai, O.; Panchagnula, R. Solid-state characterization rifampicin samples and its biopharmaceutic relevance. Eur. J. Pharm. Sci. 2004, 22, 12–144. [Google Scholar] [CrossRef] [PubMed]

| Formulation | Alginate | Gelatin | Drug | CaCl2 |
|---|---|---|---|---|
| Fibers | 2% | 2% | 50 mg | 1% |
| Formulation Code | Rifampicin in Polymeric Solution (50 mg) | Alginate (2% w/w) | PVA (0.25% v/v) | Rifampicin Loaded Fibers (Incorporated) |
|---|---|---|---|---|
| TF1 | x | ✓ | ✓ | x |
| TF2 | ✓ | ✓ | ✓ | x |
| TF3 | x | ✓ | ✓ | ✓ |
| TF4 | ✓ | ✓ | ✓ | ✓ |
| Formulation Batches | Thickness (mm) | Weight Variation (g) | Drug Content (%) | Moisture Content (%) | Moisture Uptake (%) | Folding Endurance (Folds) |
|---|---|---|---|---|---|---|
| TF1 | 0.038 ± 0.006 | 0.382 ± 0.03 | - | 17.12 ± 0.98 | 14.68 ± 0.82 | 232 ± 14 |
| TF2 | 0.039 ± 0.003 | 0.424 ± 0.05 | 96.04±0.56 | 15.14 ± 0.94 | 14.42 ± 0.72 | 268 ± 9 |
| TF3 | 0.041 ± 0.007 | 0.468 ± 0.04 | 97.61±0.42 | 12.62 ± 0.92 | 12.42 ± 0.61 | 288 ± 12 |
| TF4 | 0.043 ± 0.007 | 0.472 ± 0.08 | 98.92±0.88 | 12.21 ± 0.79 | 12.08 ± 0.82 | 298 ± 10 |
| Formulation Batch | Swelling Ratio (%) | Tensile Strength (N/mm2) | Extensibility (%) | WVTR (g/m2/h per Day) |
|---|---|---|---|---|
| TF1 | 1.92 ± 0.56 | 2.32 ± 0.45 | 15.2 ± 0.98 | 798 ± 1.28 |
| TF2 | 1.82 ± 0.42 | 2.54 ± 0.82 | 16.28 ± 0.52 | 808 ± 1.06 |
| TF3 | 4.40 ± 0.84 | 14.18 ± 0.76 | 29.18 ± 1.03 | 684 ± 1.86 |
| TF4 | 4.42 ± 9.68 | 14.32 ± 0.98 | 30.54 ± 1.08 | 692 ± 2.23 |
| Batches | Zero Order | First Order | Higuchi Model | Hixson Crowell Model | KorsmeyerPeppas Model | ||||||
|---|---|---|---|---|---|---|---|---|---|---|---|
| r2 | ko | r2 | k1 | r2 | kH | r2 | kHC | r2 | kkp | n | |
| TF2 | 0.863 | 0.143 | 0.962 | −0.013 | 0.981 | 1.554 | 0.968 | −0.016 | 0.989 | 0.391 | 0.414 |
| TF3 | 0.918 | 0.137 | 0.981 | −0.009 | 0.995 | 1.456 | 0.979 | −0.012 | 0.996 | 0.167 | 0.503 |
| TF4 | 0.951 | 0.121 | 0.960 | −0.005 | 0.986 | 1.254 | 0.949 | −0.008 | 0.985 | 0.400 | 0.760 |
| Groups | Day 2 | Day 4 | Day 6 | Day 8 | Day 10 | Day 12 | Day 14 |
|---|---|---|---|---|---|---|---|
| Wound (control group) | 17.34 ± 1.11 | 21.71 ± 2.87 | 33.82 ± 2.07 | 44.78 ± 1.88 | 58.83 ± 2.78 | 72.57 ± 5.82 | 87.74 ± 2.97 |
| Fibers (Rifampicin) | 24.32 ± 4.95 | 37.74 ± 3.96 | 57.92 ± 1.92 | 67.85 ± 3.05 | 80.92 ± 2.72 | 96.79 ± 6.43 | 98.78 ± 4.02 |
| Transdermal film (TF2) | 23.32 ± 4.91 | 35.42 ± 3.92 | 55.92 ± 1.97 | 67.81 ± 3.04 | 81.96 ± 2.73 | 95.71 ± 6.51 | 98.72 ± 4.01 |
| Transdermal Film (TF4) | 25.39 ± 4.97 | 38.77 ± 3.97 | 58.97 ± 1.96 | 68.88 ± 3.07 | 82.91 ± 2.78 | 97.78 ± 6.57 | 98.85 ± 4.04 |
| Marketed formulation (Povidone) | 33.68 ± 3.97 | 48.97 ± 4.04 | 58.09 ± 5.04 | 78.94 ± 4.07 | 91.87 ± 3.72 | 96.42 ± 2.93 | 97.12 ± 3.56 |
Publisher’s Note: MDPI stays neutral with regard to jurisdictional claims in published maps and institutional affiliations. |
© 2020 by the authors. Licensee MDPI, Basel, Switzerland. This article is an open access article distributed under the terms and conditions of the Creative Commons Attribution (CC BY) license (http://creativecommons.org/licenses/by/4.0/).
Share and Cite
Sharma, A.; Puri, V.; Kumar, P.; Singh, I. Rifampicin-Loaded Alginate-Gelatin Fibers Incorporated within Transdermal Films as a Fiber-in-Film System for Wound Healing Applications. Membranes 2021, 11, 7. https://doi.org/10.3390/membranes11010007
Sharma A, Puri V, Kumar P, Singh I. Rifampicin-Loaded Alginate-Gelatin Fibers Incorporated within Transdermal Films as a Fiber-in-Film System for Wound Healing Applications. Membranes. 2021; 11(1):7. https://doi.org/10.3390/membranes11010007
Chicago/Turabian StyleSharma, Ameya, Vivek Puri, Pradeep Kumar, and Inderbir Singh. 2021. "Rifampicin-Loaded Alginate-Gelatin Fibers Incorporated within Transdermal Films as a Fiber-in-Film System for Wound Healing Applications" Membranes 11, no. 1: 7. https://doi.org/10.3390/membranes11010007
APA StyleSharma, A., Puri, V., Kumar, P., & Singh, I. (2021). Rifampicin-Loaded Alginate-Gelatin Fibers Incorporated within Transdermal Films as a Fiber-in-Film System for Wound Healing Applications. Membranes, 11(1), 7. https://doi.org/10.3390/membranes11010007

